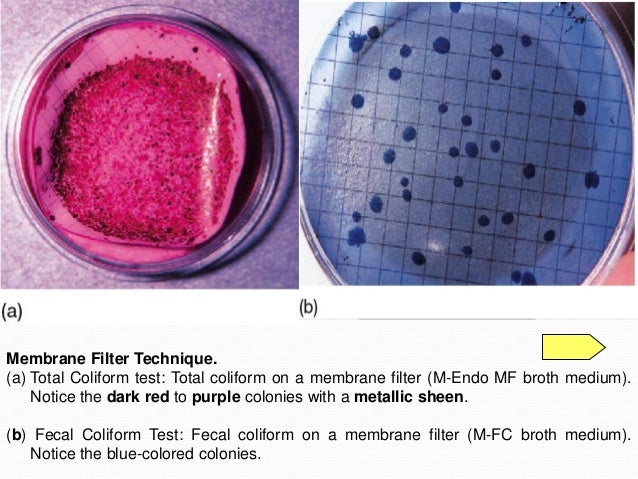
Water microbiology

If you are searching about Chlamydia trachomatis* - microbewiki you've came to the right web. We have 9 Pics about Chlamydia trachomatis* - microbewiki like What’s the difference between bacteria and viruses? - Institute for, T4 Bacteriophage and E Coli — Campbell Medical Illustration and also PPT - Influenza A Virus Structure PowerPoint Presentation, free. Here you go:
Chlamydia Trachomatis* - Microbewiki
chlamydia trachomatis structure genome microbewiki kenyon edu
Transmission Electron Microscopy Laboratory | Research Facilities Navigator
electron microscopy pedv micrograph
Video: Genome Engineering With CRISPR-Cas9 | Learn & Share | Leica
 www.leica-microsystems.com
www.leica-microsystems.com crispr cas9 genome microsystems leica engineering
Water Microbiology
www.slideshare.net
www.slideshare.net microbiology
PPT - Influenza A Virus Structure PowerPoint Presentation, Free
 www.slideserve.com
www.slideserve.com influenza virus structure ppt presentation powerpoint m2 pb2
What’s The Difference Between Bacteria And Viruses? - Institute For
 imb.uq.edu.au
imb.uq.edu.au bacteria viruses microorganisms
T4 Bacteriophage And E Coli — Campbell Medical Illustration
 www.campbellmedicalillustration.com
www.campbellmedicalillustration.com cell cancer bacteriophage phage coli animated colon t4 cells destroying giphy genome bacterial ginger gifs bacteriophages enzymes infect contribute battle
Zika Virus- Structure, Genome, Symptoms, Transmission, Pathogenesis
zika virus structure genome diagnosis pathogenesis symptoms transmission flavivirus zikv cell mosquito virology microbiology staining visit
Evolution - Variations In Genome Sizes - Biology Stack Exchange
 biology.stackexchange.com
biology.stackexchange.com genome sizes value variations paradox pairs base bacteria microbiology variation dna fish larger organisms biology evolution graph diagram genes boundless
Cell cancer bacteriophage phage coli animated colon t4 cells destroying giphy genome bacterial ginger gifs bacteriophages enzymes infect contribute battle. Video: genome engineering with crispr-cas9. What’s the difference between bacteria and viruses?